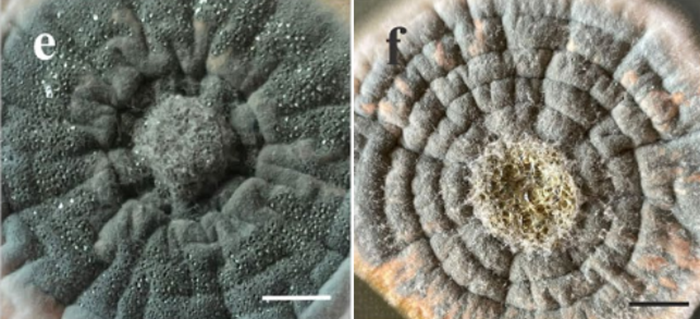

世界提高抗微生物药物认识周
2025-11-17 11:15
成都市新津区人民医院
抗微生物药物认识周:那些看不见的“盟友”与一场正在输掉的战争
世界提高抗微生物药物认识周
2025年11月18日-24日

当你听到“微生物”这三个字,第一反应是什么?是导致感冒的病毒,还是让食物变质的细菌?或许,在你的印象里,它们更多是疾病的元凶。
但在我们肉眼无法观测的微观世界里,也存在着无数与我们并肩作战的“微生物盟友”。正是它们,创造了人类医学史上最伟大的武器之一抗微生物药物。本周是“抗微生物药物认识周”,让我们一起了解这些看不见的盟友,并正视一场我们正在逐渐输掉的战争——微生物耐药性。
一、奇迹的开端:一个发霉的盘子
1928年,亚历山大·弗莱明发现一个被青霉菌污染的培养皿中,细菌的生长被抑制了。这个偶然的观察,最终催生了青霉素的诞生。
青霉素,是人类发现的第一种能高效杀死细菌且对人体伤害较小的物质。它的问世,标志着抗生素时代的开启。从此,无数曾被视为绝症的感染性疾病——肺炎、结核、败血症、梅毒等——得到了有效控制。在二战战场上,青霉素拯救了无数伤员的生命,被誉为“救命神药”。
青霉菌菌落外观(图片来源:Araújo et al., 2024, Braz J Microbiol)
而青霉素,正是一种典型的抗微生物药物——由微生物(这里是青霉菌)产生,并能抑制或杀死其他微生物的化学物质。
二、微观世界的“军备竞赛”:微生物药物的宝库
自然界中的微生物(主要是放线菌、真菌等)为了争夺生存空间和资源,会分泌出各种化学物质来抑制或消灭竞争对手。科学家们从土壤、水体等自然环境中分离这些微生物,筛选出它们所产生的、具有药理活性的物质,经过提纯和改造,就成为了我们药箱里的各种抗生素、抗真菌药,甚至抗癌药物。
链霉素:来自土壤中的链霉菌,是抗击结核病的关键武器。
四环素:同样来自放线菌,是一种广谱抗生素。
他克莫司:一种来自放线菌的强大免疫抑制剂,使器官移植成为可能。
可以说,我们手中的每一粒抗生素药片,背后都站着一群默默无闻的微生物“盟友”。它们是大自然赐予我们的珍贵礼物。
三、寂静的危机:当“盟友”失效,我们正在输掉的战争
然而,这份礼物正被我们滥用和透支。微生物是进化的大师,繁殖速度快,在药物的“自然选择”压力下,耐药菌——也就是那些发生了变异、不再害怕抗生素的细菌——存活了下来并大量繁殖。
是什么在加速耐药性的蔓延?
1. 滥用与过度使用:感冒、流感等病毒性感染使用抗生素无效,但很多人仍会要求医生开药。
2. 用药不规范:症状稍有好转就擅自停药,未能彻底清除细菌,反而“锻炼”了残存的耐药菌。
3. 农业与畜牧业的滥用:在动物饲料中添加抗生素以促进生长,导致耐药菌通过食物链传递给人。
4. 医院内的交叉感染:医院是耐药菌产生和传播的温床。
世界卫生组织已明确指出,抗生素耐药性是当今全球公共卫生、食品安全和发展面临的最大威胁之一。如果我们不采取行动,未来一个普通的感染或轻微的外伤,都可能再次变得致命,我们将进入一个“后抗生素时代”。
四、我们能做什么?成为守护“盟友”的战士
这场战争没有旁观者。我们每个人的行动,都至关重要。在此,我们向每一位读者发出倡议:
不自行购买:绝不自行去药店购买抗生素。抗生素是处方药,必须由医生诊断后开具。
不主动要求:看医生时,不主动要求使用抗生素。相信医生的专业判断。
不随意停药:一旦开始服用,必须严格遵医嘱,完成整个疗程,即使感觉已经好转。
不分享药物:不把自己未用完的抗生素给他人使用,因为病因可能不同。
讲卫生:经常洗手,使用疫苗,预防感染的发生,是从源头上减少抗生素使用的最佳方法。
结语
微生物药物认识周,不仅是为了感恩那些看不见的微观盟友,更是为了拉响捍卫我们共同未来的警报。
这些拯救了无数生命的珍贵药物,并非取之不尽。它们的效力,也并非永恒。守护这份来自微观世界的礼物,就是守护我们自己在未来免于无药可医的困境。
从现在做起,从我做起,合理使用抗生素,为后代留住这些生命的防火墙。
作者:钟晶
成都市新津区人民医院药剂科临床药师(主管药师)
曾于四川省人民医院进修呼吸内科临床药师1年
主要研究方向:抗感染、呼吸内科慢病管理
现任:四川省执业药师协会药物治疗委员会委员、四川省老年医学会临床药学专委会委员、四川省执业药师协会社会药房药物治疗管理(MTM)实训基地带教老师

唐仕炜副主任药师,成都市新津区人民医院药学部主任
现任:中国药理学会治疗药物监测研究专业委员会基层医院委员会委员
《中国药物警戒》杂志审稿专家
四川省医院协会药事管理专业委员会委员
四川省生物信息学学会智慧药学服务分会委员
主持四川省卫计委课题1项,参与多项省市级课题
近年来发表SCI 4篇,科技核心8篇,授权实用新型专利6项


成都市新津区人民医院药学部现有工作人员共28名,其中高级职称4人、中级职称16人、初级职称8人;具备本科及以上学历者占比超过50%,包括博士1人、硕士6人、本科15人。 部门下设综合药房、中药房、药库、临床药学室等多个职能小组,组织架构完善。
科室业绩突出,屡获殊荣,多次被医院评为“先进集体”,并先后荣获新津区“青年文明号”、新津区卫健局“十佳青年文明号”窗口,以及成都市药监局“药物不良反应监测先进集体”等称号。
在专业建设方面,药学部承担医院国家药物临床试验机构的日常运行与管理工作,并于2023年成为四川省执业药师协会在三级医疗机构中设立的首家MTM(药物治疗管理)培训基地。此外,新院区正在建设一个占地面积达900余平方米的静脉药物调配中心(PIVAS)。凭借其显著的规模优势,该中心建成投运后,将有望成为四川省区县级医院中,大规模开展静脉用药集中调配业务的核心力量之一。
2025年11月,医院正式授牌成为“四川省药品不良反应监测哨点医院”,标志着医院在用药安全保障方面迈上了新的台阶,也肩负起更为重要的责任使命。

